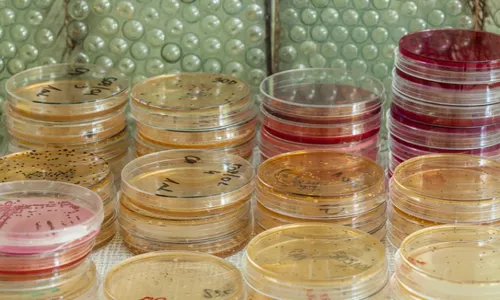
Imagem ilustrativa da imagem OMS alerta para aumento de casos de cólera no mundo

OMS alerta para aumento de casos de cólera no mundo
Crescimento foi de 25% em relação a 2021
A Organização Mundial da Saúde (OMS) emitiu um alerta esta semana para o aumento de casos de cólera no mundo. De acordo com a entidade, em 2022, foram registrados mais que o dobro de casos da doença que em 2021 – 472.697 contra 223.370. Além disso, 44 países reportaram notificações da doença – um aumento de 25% em relação aos 35 países que reportaram casos em 2021.
“Não só houve mais surtos, mas os surtos foram maiores”, destacou a OMS. Os dados mostram que sete países – Afeganistão, Camarões, República Democrática do Congo, Malawi, Nigéria, Somália, Síria e República Árabe – reportaram mais de 10 mil casos suspeitos ou confirmados no ano passado. “Quanto maior o surto, mais difícil é normalmente controlá-lo”.
Os números sugerem que, em 2023, o aumento de casos deve se manter – atualmente, 24 países já confirmaram surtos de cólera em andamento, sendo que alguns deles enfrentam o que a OMS chama de “crises agudas” provocadas pela doença.
A entidade lembrou que a cólera é uma infecção intestinal aguda que se espalha através de alimentos e água contaminados com fezes contendo a bactéria Vibrio cholerae e que o quadro está intimamente ligado à falta de água potável e saneamento adequado, à pobreza e aos conflitos.
“As alterações climáticas também desempenham seu papel neste recrudescimento, uma vez que acontecimentos climáticos extremos, como inundações, secas e ciclones desencadeiam novos surtos e agravam os já existentes.”
Além disso, o aumento na procura por mecanismos de combate à cólera configura o que a entidade classifica como desafio para os esforços no controle de doenças em todo o mundo.
Desde outubro do ano passado, o Grupo de Coordenação Internacional (ICG, na sigla em inglês), organismo que gere o abastecimento de emergência de vacinas – optou por suspender o esquema padrão de vacinação em duas doses nas campanhas de resposta a surtos de cólera, utilizando, em vez disso, uma abordagem com dose única.
MATÉRIAS RELACIONADAS:
















Comentários